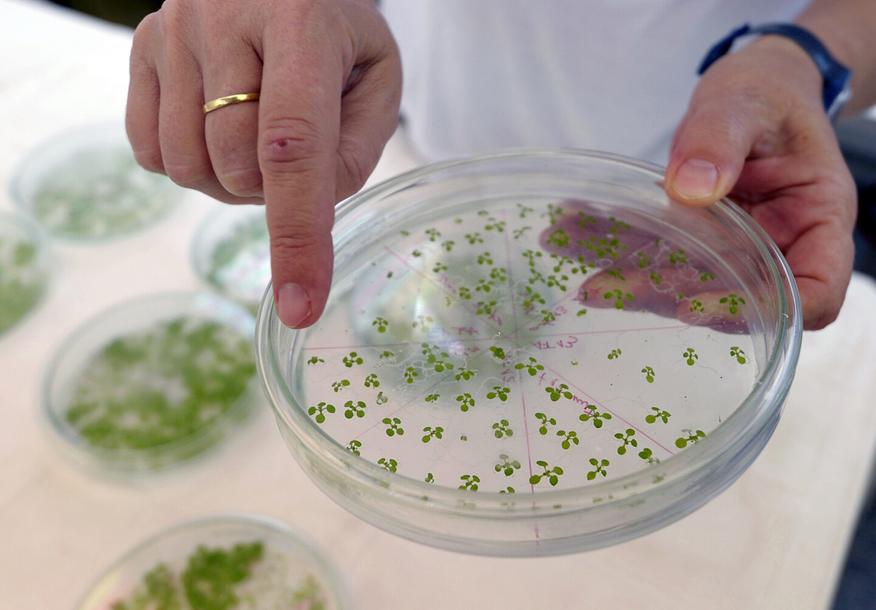

Учёные создали растения, которые поглощают вдвое больше углекислого газа
Исследователи из Тайваня разработали принципиально новый биохимический механизм для растений, позволяющий им более эффективно поглощать углекислый газ из атмосферы. Созданный ими малик-КоА-глицериновый цикл (сокращённо цикл МГ) представляет собой искусственный метаболический путь, состоящий из восьми реакций, катализируемых ферментами из разных видов, которые в природе вместе не встречаются.
В отличие от традиционного цикла Кальвина, используемого растениями для фотосинтеза, новый цикл МГ захватывает углерод на двух разных этапах и производит двухуглеродные молекулы, которые растения могут напрямую использовать для синтеза липидов без необходимости повторного выделения CO₂. Цикл также способен обмениваться молекулами с циклом Кальвина, что позволяет этим двум системам эффективно взаимодействовать.
Эксперименты на арабидопсисе (резуховидке Таля) показали впечатляющие результаты: растения с внедрённым циклом МГ весили в 2-3 раза больше контрольных образцов, имели больше листьев, которые сами были крупнее, и производили больше семян. При этом их потребность в воде не увеличилась.
Особенно заметным оказалось увеличение производства липидов — уровень триглицеридов вырос в 100 и более раз, что привело к образованию в клетках растений специальных карманов, заполненных жировыми веществами.

Хотя исследование проводилось в лабораторных условиях на модельном растении, эта технология потенциально может найти применение в создании более эффективных биотопливных культур или в разработке растений, способных интенсивнее поглощать атмосферный углерод для смягчения последствий изменения климата. Однако учёным ещё предстоит выяснить, насколько эти результаты применимы к сельскохозяйственным культурам и деревьям в реальных полевых условиях.
Источник: Ars Technica











0 комментариев
Добавить комментарий